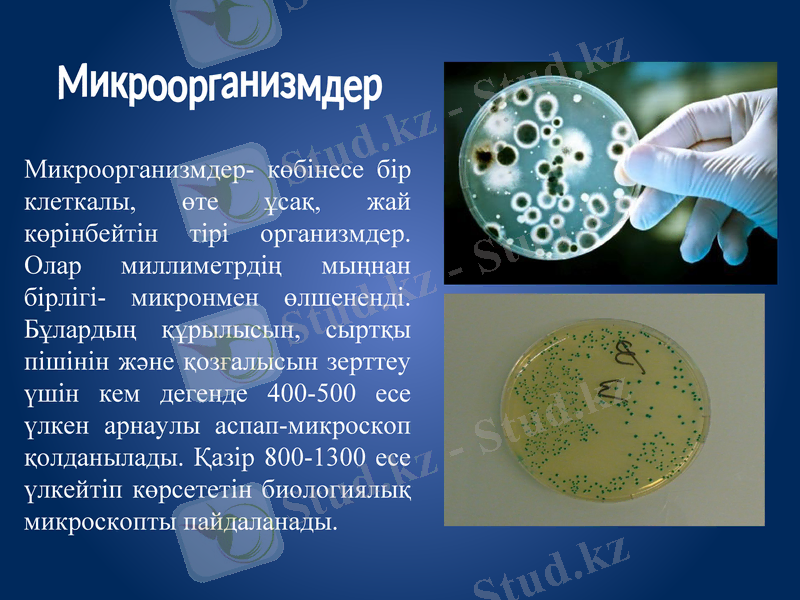
Slide 3
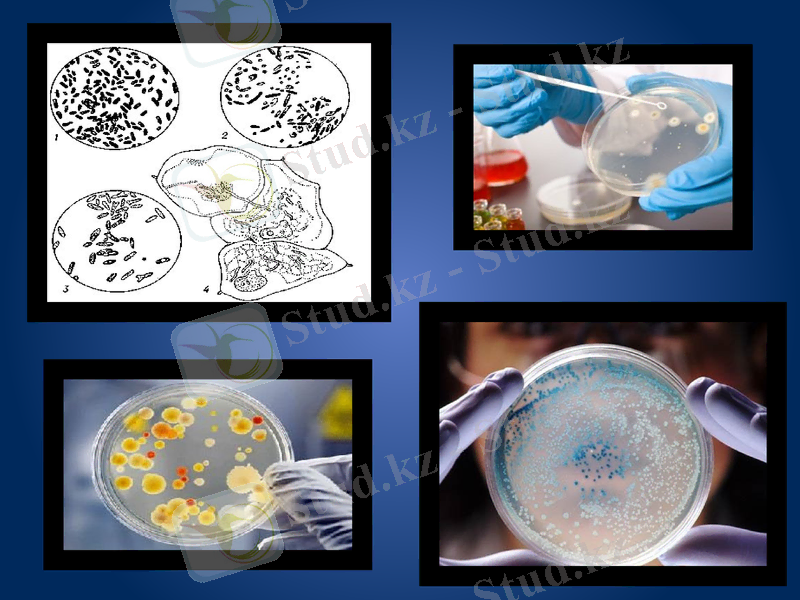
Slide 8

Клеткалық микроағзалардың құрылымы, түрлері және өндірістік қолданылуы



ҚАЗАҚСТАН РЕСПУБЛИКАСЫ БІЛІМ ЖӘНЕ ҒЫЛЫМ МИНИСТРЛІГІ СЕМЕЙ қаласының ШӘКӘРІМ атындағы МЕМЛЕКЕТТІК УНИВЕРСИТЕТІ
Тақырыбы: Клетка микроағзалардың структурасы
Орындаған: Төлеубаева С.
Группа: БТ ̶ 307

Жоспар
Микроорганизмдер және олардың түрлері
Микроорганизмдер процесі және әсері
Өндірісте қолданылатын микроорганизмдер
Микробиологияның дамуы
Бактериялардың формалары
Микроорганизмдер- көбінесе бір клеткалы, өте ұсақ, жай көрінбейтін тірі организмдер. Олар миллиметрдің мыңнан бірлігі- микронмен өлшененді. Бұлардың құрылысын, сыртқы пішінін және қозғалысын зерттеу үшін кем дегенде 400-500 есе үлкен арнаулы аспап-микроскоп қолданылады. Қазір 800-1300 есе үлкейтіп көрсететін биологиялық микроскопты пайдаланады.
Микроорганизмдер

Микроорганизмдерге

Техникалық немесе өнеркәсіптік микробиология - микроптардың тіршілігі нәтижесінде түзілетін өнімдердің адам баласына ең қажеттілерін іс жүзінде өндізудің ғылыми негіздерін жасайды, оларды көптеп өндіруді қарастырады. Техникалық микробиологияның дамуы барысында ашыту өнеркәсібі, антибиотиктерді, ферменттерді, витаминдерді, амин қышқылдарын өндіретін өндірістер ұйымдастырылады.


Микробиология тарихында римнің профессоры Афанаси Қирхердің (1601-1680) есімі де аталуы тиіс. Қирхер сасыған ет, щарап сіркесін, сүтті қарап, онда түрлі құрттардың кездесетінің байқады. Ол қанды қарап, онда түрлі клеткаларды көреді.
Микробиология тарихында римнің профессоры

Қарапайымдылар бактерияларға қарағанда күрделі дамыған. 4 классқа жіктеледі:70 мың түрлері бар.
1. Саркодиналар класы-тынымсыз қозғалады, қабықшасы болмайды, дене пішіні тұрақсыз, бөліну арқылы көбейеді.
2. Спорофиттер(Sporozoa) - жынысты және жыныссыз жолмен көбейеді, арнайы қозғалу органы жоқ.
3. Жгутиктілер(Flogollata) -овал және шар тәрізді, белсенді қозғалады. Бөліну арқылы көбейеді.
4. Талшықтар(Infusoria) -инфузориялар кірпікшелер арқылы қозғалады, адамда ішек инфузориясы кездеседі.
- Іс жүргізу
- Автоматтандыру, Техника
- Алғашқы әскери дайындық
- Астрономия
- Ауыл шаруашылығы
- Банк ісі
- Бизнесті бағалау
- Биология
- Бухгалтерлік іс
- Валеология
- Ветеринария
- География
- Геология, Геофизика, Геодезия
- Дін
- Ет, сүт, шарап өнімдері
- Жалпы тарих
- Жер кадастрі, Жылжымайтын мүлік
- Журналистика
- Информатика
- Кеден ісі
- Маркетинг
- Математика, Геометрия
- Медицина
- Мемлекеттік басқару
- Менеджмент
- Мұнай, Газ
- Мұрағат ісі
- Мәдениеттану
- ОБЖ (Основы безопасности жизнедеятельности)
- Педагогика
- Полиграфия
- Психология
- Салық
- Саясаттану
- Сақтандыру
- Сертификаттау, стандарттау
- Социология, Демография
- Спорт
- Статистика
- Тілтану, Филология
- Тарихи тұлғалар
- Тау-кен ісі
- Транспорт
- Туризм
- Физика
- Философия
- Халықаралық қатынастар
- Химия
- Экология, Қоршаған ортаны қорғау
- Экономика
- Экономикалық география
- Электротехника
- Қазақстан тарихы
- Қаржы
- Құрылыс
- Құқық, Криминалистика
- Әдебиет
- Өнер, музыка
- Өнеркәсіп, Өндіріс
Қазақ тілінде жазылған рефераттар, курстық жұмыстар, дипломдық жұмыстар бойынша біздің қор #1 болып табылады.



Ақпарат
Қосымша
Email: info@stud.kz